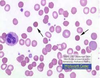

Pathophysiology Flashcards
(36 cards)
Canine AIHA or IMHA stands for?
Auto-Immune Hemolytic Anemia or immune-mediated hemolytic anemia
What occurs with IMHA or AIHA?
Immune mediated hemolytic anemia is one of the most prevalent immune mediated disorders in dogs and cats. It is a condition whereby the red blood cells become coated with immunoglobulins (antibodies), leading to the premature destruction of these red blood cells by the animal’s own body. Coated red blood cells will be destroyed (hemolysed) either within the blood stream or by specialized white blood cells (macrophages) within the spleen or liver.
“Autoimmune hemolytic anemia (AIHA) is an immune system disease in which the body attacks and destroys its own red blood cells.”
What are some clinical signs of IMHA or AIHA?
anorexia, lysing RBCs in vascular system, icterus (jaundice), listlessness, weakness, depression, tachycardia, tachypnea, pale mucous membranes
What is found on blood smear with AIHA and IMHA?
spherocytes
What test can you run to test for AIHA or IMHA?
Coomb’s test - must be species specific
What is a Coomb’s test?
A Coombs’ (or direct antiglobulin) test detects the presence of immunoglobulins (antibodies) on the surface of red blood cells.The Coombs’ test detects these immunoglobulins using specific antiserum that reacts against different types of immunoglobulins. If this antiserum detects immunoglobulins on the surface of the red blood cells, it will cause the red blood cells to agglutinate or clump in the test tube.
What are immunoglobulins?
Immunoglobulins are proteins made by white blood cells (specifically plasma cells).
What does a positive Coomb’s test result mean?
means that the red blood cells are coated with hundreds of immunoglobulins. A positive result, taken along with other corroborative laboratory data and clinical signs, is supportive of immune mediated destruction of red blood cells. However, a positive Coombs’ test does not allow us to determine if the red blood cell destruction is due to primary or secondary immune mediated hemolysis.
Because positive Coombs’ test results can sometimes occur in animals without immune mediated hemolytic anemia, it is important to determine whether the CBC and serum biochemistry panels contain supportive evidence for immune mediated red blood cell destruction.
What does a negativeCoomb’s test result mean?
it can indicate that your pet does not have immune mediated hemolytic anemia. However, it is important to know that a false negative Coombs’ test result is seen in approximately 10% to 30% of dogs with immune mediated hemolytic anemia. False negatives occur because red blood cell hemolysis can occur with as few as 20 to 30 molecules of antibody attached to the red blood cell, whereas the Coombs’ test requires the presence of more than 200 to 300 molecules before a positive result is noted.
Recent treatment with steroids may cause a Coombs’ test to be falsely negative.
What are treatments for AIHA or IMHA?
If your dog’s anemia is so severe that it is life-threatening, a blood transfusion will be needed. Before giving a transfusion, blood samples will be taken for diagnostic testing. The main purpose of a blood transfusion is to stabilize the dog while the underlying cause of the anemia is determined and other treatments can begin to take effect.
If the AIHA is secondary, the treatment will be directed at the underlying cause. If no underlying cause can be detected, or if the disease is determined to be primary or idiopathic AIHA, immunosuppressive therapy will be used. In some cases of idiopathic AIHA, the dog will respond rapidly to treatment with immunosuppressive doses of corticosteroids. In other cases, the patient may require a combination of immunosuppressive medications to get the condition under control.
What is Canine Idiopathic Thrombocytopenic Purpura?
Aka - Immune-Mediated Thrombocytopenia(IMTP) or idiopathic thrombocytopenia
occurs when platelets become coated with antibodies complexes. Desctruction may occur in the spleen, bone marrow, or liver
What are some clinical signs of canine idipathic thrombocytopenic purpura?
petechial and ecchymotic hemorrhages on skin and mocosal surfaces, earflaps and other mucocutaneous surfaces. Bloody stool or blood in vomitus is seen occasionally
platelets decline to less than 30,000

What is Evans syndrome?
Evans syndrome is the presence of simultaneous or sequential direct Coombs-positive autoimmune hemolytic anemia (AIHA) in conjunction with immune-mediated thrombocytopenia, with no known underlying etiology.
What are clinical signs of Evan’s syndrome?
Manifestations of Evans syndrome may include the following, in descending order of frequency:
Thrombocytopenia
Anemia
Neutropenia
Pancytopenia
Signs of thrombocytopenia include purpura, petechiae, and ecchymoses. Signs of anemia include pallor, fatigue, and light-headedness. Jaundice may indicate hemolysis.
Potential complications of Evans syndrome include the following:
Hemorrhage with severe thrombocytopenia
Serious infection in patients with neutropenia
Self vs. non-self?
RBCs; AIHA
Platelets; IMTP
AIHA + IMTP = Evans Syndrome
Synovia; Rheumatoid Arthritis - synovium tissue that lines the joint cavity (loses lubricant)
Spherocytes vs Erythrocytes
Thyroid - autoimmune - thyroid gland enlargement
joint taps send to lab
What is autoimmune dermal necrolysis?
living skin cells (basal layers) - llike a burn but came from inside, skin broke down -sloughing diseases
What is De Pigmentation Lesions?
attack on cells that make pigment
What is Canine Rheumatoid Arthritis?
Immune activated destruction of:
Synovium - attached as a tissue, structure
Cartilage - leisions - attacks it - breaks down - bone on bone- missing cartilage - complete complapse in the tarsus, metacarpus, phallages
Reduced lubricity of the synovial joint fluid - eroded by lack of lubricant
What is blood loss anemia?
Acute blood loss can lead to shock and even death if >30–40% of blood is lost and the hypovolemia that develops is not treated aggressively with IV fluids or compatible blood, or both.
low hematocrit
20% nomral threshold needs transfusion
iron measurement, cells are small, deficient on iron
parasites - flea bite anemia
blood loss in gut -
What is normal hematocrit PVS in a dog?
37% to 55%
What is hypvolemia?
state of decreased blood volume
What are the causes of blood loss anemia?
Causes of acute loss can be known (eg, trauma, surgery) or occult. GI parasites, such as Haemonchus in ruminants and hookworms in dogs, can lead to severe blood loss, especially in young animals. Low-grade, chronic blood loss eventually results in iron-deficiency anemia, although some degree of reticulocytosis may persist even after iron stores become depleted.
What is iron deficiency anemia?
The hallmark of an iron-deficiency anemia is a microcytic, hypochromic anemia. This chronic blood loss can be due to some type of parasitism in young animals (fleas, lice, intestinal parasitism), but in older animals, bleeding from GI ulcers or tumors is more common.
What is hypochromic, microcytic anemias?
Hypochromic, microcytic anemias are the result of impaired hemoglobin production, typically as a consequence of defects in globin gene expression, as in systemic iron deficiency.